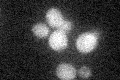
YMR163C
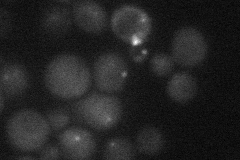
YMR163C

View description
Peroxisome-specific receptor important for peroxisome inheritance; co-fractionates with peroxisome membranes and co-localizes with peroxisomes in vivo; physically interacts with the myosin V motor Myo2p; INP2 is not an essential gene
Localization:
Intensity:
Fold change:
Significance:
-
C’ GFP library in SD
cytosol19.2 -
N' NOP1pr-GFP in SD

punctate28.4711 -
N' TEF2pr-mCherry in SD
punctate13.1873 -
N' NATIVEpr-GFP in SD

punctate15.8343 -
N' TEF2pr-VC and Cyto-VN in SD

below threshold25.6184 -
C’ GFP library in SD+DTT

cytosol16.710.87No -
C’ GFP library in SD+H2O2

cytosol17.770.92No -
C’ GFP library in Starvation Media

cytosol14.720.76No -
C’ GFP library on the background of Pup2-DaMP

cytosol -
C’ GFP library on the background of CCT mutant

cytosol19.30681.0055No
